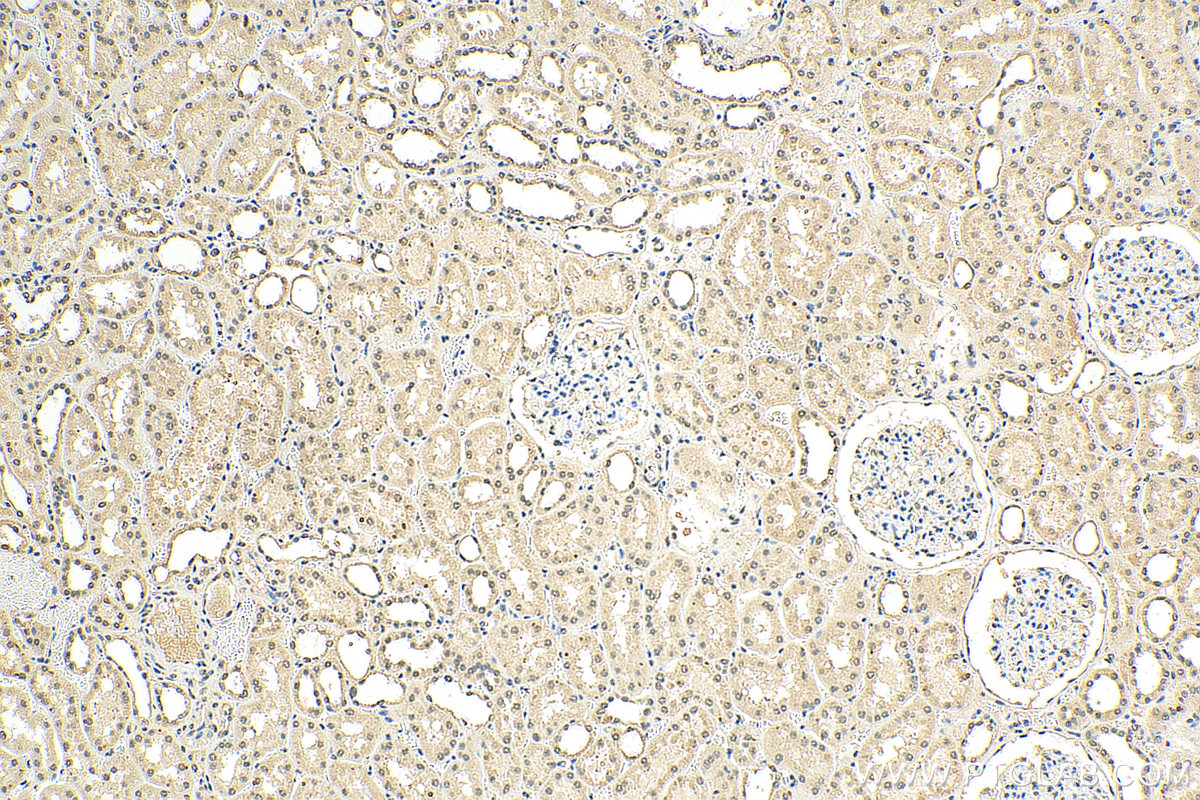

验证数据展示
经过测试的应用
| Positive WB detected in | pig brain tissue, pig kidney tissue, rat brain tissue, rat kidney tissue, mouse brain tissue, mouse skeletal muscle tissue |
| Positive IHC detected in | mouse cerebellum tissue, human kidney tissue Note: suggested antigen retrieval with TE buffer pH 9.0; (*) Alternatively, antigen retrieval may be performed with citrate buffer pH 6.0 |
推荐稀释比
| 应用 | 推荐稀释比 |
|---|---|
| Western Blot (WB) | WB : 1:500-1:3000 |
| Immunohistochemistry (IHC) | IHC : 1:50-1:500 |
| It is recommended that this reagent should be titrated in each testing system to obtain optimal results. | |
| Sample-dependent, Check data in validation data gallery. | |
发表文章中的应用
| KD/KO | See 1 publications below |
| WB | See 11 publications below |
产品信息
66478-1-Ig targets SMAD7 in WB, IHC, IF/ICC, ELISA applications and shows reactivity with Human, mouse, rat, pig samples.
| 经测试应用 | WB, IF, IHC, ELISA Application Description |
| 文献引用应用 | WB |
| 经测试反应性 | Human, mouse, rat, pig |
| 文献引用反应性 | human, mouse, rat |
| 免疫原 |
CatNo: Ag13688 Product name: Recombinant human SMAD7 protein Source: e coli.-derived, PET28a Tag: 6*His Domain: 1-426 aa of BC074819 Sequence: MFRTKRSALVRRLWRSRAPGGEDEEEGAGGGGGGGELRGEGATDSRAHGAGGGGPGRAGCCLGKAVRGAKGHHHPHPPAAGAGAAGGAEADLKALTHSVLKKLKERQLELLLQAVESRGGTRTACLLLPGRLDCRLGPGAPAGAQPAQPPSSYSLPLLLCKVFRWPDLRHSSEVKRLCCCESYGKINPELVCCNPHHLSRLCELESPPPPYSRYPMDFLKPTADCPDAVPSSAETGGTNYLAPGGLSDSQLLLEPGDRSHWCVVAYWEEKTRVGRLYCVQEPSLDIFYDLPQGNGFCLGQLNSDNKSQLVQKVRSKIGCGIQLTREVDGVWVYNRSSYPIFIKSATLDNPDSRTLLVHKVFPGFSIKAFDYEKAYSLQRPNDHEFMQQPWTGFTVQISFVKGWGQCYTRQFISSCPCWLEVIFNSR 种属同源性预测 |
| 宿主/亚型 | Mouse / IgG2b |
| 抗体类别 | Monoclonal |
| 产品类型 | Antibody |
| 全称 | SMAD family member 7 |
| 别名 | CRCS3, hSMAD7, MAD homolog 7, MAD homolog 8, MADH7, MADH8, Mothers against DPP homolog 7, Mothers against DPP homolog 8, SMAD 7, SMAD family member 7, SMAD7 |
| 计算分子量 | 426 aa, 46 kDa |
| 观测分子量 | 50 kDa |
| GenBank蛋白编号 | BC074819 |
| 基因名称 | SMAD7 |
| Gene ID (NCBI) | 4092 |
| RRID | AB_2881844 |
| 偶联类型 | Unconjugated |
| 形式 | Liquid |
| 纯化方式 | Protein A purification |
| UNIPROT ID | O15105 |
| 储存缓冲液 | PBS with 0.02% sodium azide and 50% glycerol, pH 7.3. |
| 储存条件 | Store at -20°C. Stable for one year after shipment. Aliquoting is unnecessary for -20oC storage. |
背景介绍
SMAD7, also named as Mothers against decapentaplegic homolog 7, is a 426 amino acid protein, which belongs to the dwarfin/SMAD family. SMAD7 Interaction with NEDD4L or RNF111 induces translocation from the nucleus to the cytoplasm (PubMed:16601693). TGF-beta stimulates its translocation from the nucleus to the cytoplasm. PDPK1 inhibits its translocation from the nucleus to the cytoplasm in response to TGF-beta (PubMed:17327236). SMAD7 as antagonist of signaling by TGF-beta (transforming growth factor) type 1 receptor superfamily members has been shown to inhibit TGF-beta (Transforming growth factor) and activin signaling by associating with their receptors thus preventing SMAD2 access. SMAD7 functions as an adapter to recruit SMURF2 to the TGF-beta receptor complex and also acts by recruiting the PPP1R15A-PP1 complex to TGFBR1, which promotes its dephosphorylation. SMAD7 positively regulates PDPK1 kinase activity by stimulating its dissociation from the 14-3-3 protein YWHAQ which acts as a negative regulator.
实验方案
| Product Specific Protocols | |
|---|---|
| IHC protocol for SMAD7 antibody 66478-1-Ig | Download protocol |
| WB protocol for SMAD7 antibody 66478-1-Ig | Download protocol |
| Standard Protocols | |
|---|---|
| Click here to view our Standard Protocols |
发表文章
| Species | Application | Title |
|---|---|---|
Acta Pharmacol Sin The multifunctional adaptor protein HIP-55 couples Smad7 to accelerate TGF-β type I receptor degradation.
| ||
Aging (Albany NY) LINC00968 can inhibit the progression of lung adenocarcinoma through the miR-21-5p/SMAD7 signal axis. | ||
Biomed Pharmacother Yu Gan Long reduces rat liver fibrosis by blocking TGF-β1/Smad pathway and modulating the immunity. | ||
J Ethnopharmacol Wu-Mei-Wan ameliorates chronic colitis-associated intestinal fibrosis through inhibiting fibroblast activation. | ||
Exp Cell Res Exosomes derived from thymic stromal lymphopoietin-treated dendritic cells regulate T helper 17/regulatory T cell differentiation via miR-21/Smad7 axis. | ||
Biochem Biophys Res Commun Emodin ameliorates tubulointerstitial fibrosis in obstructed kidneys by inhibiting EZH2. |